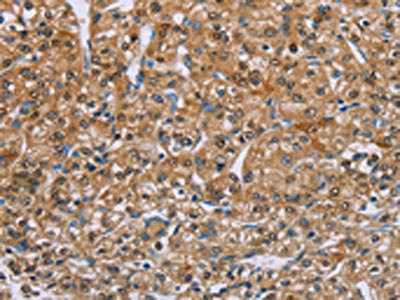

PSCA Antibody
-
中文名稱:PSCA兔多克隆抗體
-
貨號:CSB-PA058956
-
規(guī)格:¥1100
-
圖片:
-
The image on the left is immunohistochemistry of paraffin-embedded Human prostate cancer tissue using CSB-PA058956(PSCA Antibody) at dilution 1/40, on the right is treated with synthetic peptide. (Original magnification: ×200)
-
Gel: 10%SDS-PAGE, Lysate: 40 μg, Lane: Mouse stomach tissue, Primary antibody: CSB-PA058956(PSCA Antibody) at dilution 1/200, Secondary antibody: Goat anti rabbit IgG at 1/8000 dilution, Exposure time: 5 minutes
-
-
其他:
產品詳情
-
Uniprot No.:
-
基因名:
-
別名:PSCA antibody; UNQ206/PRO232 antibody; Prostate stem cell antigen antibody
-
宿主:Rabbit
-
反應種屬:Human,Mouse
-
免疫原:Synthetic peptide of Human PSCA
-
免疫原種屬:Homo sapiens (Human)
-
標記方式:Non-conjugated
-
抗體亞型:IgG
-
純化方式:Antigen affinity purification
-
濃度:It differs from different batches. Please contact us to confirm it.
-
保存緩沖液:-20°C, pH7.4 PBS, 0.05% NaN3, 40% Glycerol
-
產品提供形式:Liquid
-
應用范圍:ELISA,WB,IHC
-
推薦稀釋比:
Application Recommended Dilution ELISA 1:1000-1:2000 WB 1:200-1:1000 IHC 1:50-1:200 -
Protocols:
-
儲存條件:Upon receipt, store at -20°C or -80°C. Avoid repeated freeze.
-
貨期:Basically, we can dispatch the products out in 1-3 working days after receiving your orders. Delivery time maybe differs from different purchasing way or location, please kindly consult your local distributors for specific delivery time.
-
用途:For Research Use Only. Not for use in diagnostic or therapeutic procedures.
相關產品
靶點詳情
-
功能:May be involved in the regulation of cell proliferation. Has a cell-proliferation inhibition activity in vitro.; May act as a modulator of nicotinic acetylcholine receptors (nAChRs) activity. In vitro inhibits nicotine-induced signaling probably implicating alpha-3:beta-2- or alpha-7-containing nAChRs.
-
基因功能參考文獻:
- The decreased PSCA m-RNA levels were involved in the progress of bladder cancer. T allele takes more responsibility for PSCA m-RNA down-regulation to promote cell proliferation and migration and hinder cell apoptosis, thus leading to a higher risk. PMID: 29892961
- Men with the rs1045531 AC genotype of prostate stem cell antigen(PSCA) were at higher risk of prostate cancer in Chinese patients undergoing prostate biopsy. PMID: 29332451
- Study shows that PSCA gene is a target of 8q24 locus in Invasive micropapillary carcinoma (IMPC) of the breast, and the PSCA gene amplification results in PSCA protein overexpression. These results demonstrate an independently worse prognosis for PSCA overexpression in IMPC, and suggest that the differential expression of PSCA is associated with cell adhesion molecules in breast cancer. PMID: 28755148
- the PSCA rs2294008 polymorphism may serve as a biomarker of cervical cancer, particularly of early-stage cervical cancer PMID: 27001215
- The expression of Ki-67, PSCA, and Cox-2 biomarkers along with other clinicopathologic factors were prognostic factors for biochemical recurrence in patients with clinically localized prostate cancer following radical prostatectomy PMID: 27232854
- Among Chinese Han women, the PSCA rs2294008, rs2978974, and rs2976392 minor alleles are associated with increased breast cancer risk especially in progesterone receptor positive breast cancer patients, with breast cancer risk in postmenopausal women, and with high lymph node metastasis risk, respectively. PMID: 27050280
- PSCA is a novel cell cycle regulator with a key role in prostate cancer cell proliferation. PMID: 28971496
- PSCA regulates IL-6 expression through p38/NF-kappaB signaling in Prostate cancer. PMID: 28845520
- the results indicated that the PSCA rs2294008 T and rs2976392 A alleles were low-penetrate risk factors for gastric cancer in this study population. PMID: 26848528
- analysis of PSCA level in the peripheral blood of PC patients who underwent radical prostatectomy shows it is related to a GADPH reference level (PSCA/GAPDH ratio) PMID: 26527100
- our data provide a novel molecular mechanism for the tumor suppressor role of PSCA PMID: 26785734
- suggest that PSCA is a useful tissue marker for predicting biochemical recurrence in patients with high risk PC receiving NHT and radical prostatectomy PMID: 26982980
- Genetic Variants of PSCA Gene are not Associated with Colorectal Cancer. PMID: 26320491
- we show that PSCA is a key player in nasopharyngeal carcinoma metastasis PMID: 26147638
- PSCA rs2294008 Polymorphism is associated with Increased Risk of Cancer PMID: 26308216
- PSCA has a promoting role in the growth and metastasis of prostate cancer. PMID: 26477693
- PSCA mRNA is overexpressed in the peripheral blood of prostate cancer patients. PMID: 25698533
- These results suggest that PSCA gene variation has a potential effect on its expression and gastric adenocarcinoma risk in the Northwest Chinese population. PMID: 26006239
- a significantly increased stomach cancer risk was associated with PSCA SNPs rs2294008 and s2976392 in a Han Chinese population. PMID: 25658482
- Studied six SNP loci: (rs2279115 of BCL2 gene, rs804270 of NEIL2 gene, rs909253 of LTA gene, rs2294008 of PSCA gene, rs3765524 and rs10509670 of PLCE1 gene) to evaluate gastric cancer risk using magnetic nanoparticles and universal tagged arrays. PMID: 26554163
- The PSCA rs2294008 C>T polymorphism may be acting through induction of gastric mucosal atrophy, finally leading to development of gastric ulcer and gastric cancer in PSCA rs2294008 T allele carriers with Helicobacter infections. PMID: 25582162
- The PSCA rs2294008 polymorphism is involved in the susceptibility to GC and DU. PMID: 25721731
- PSCA signaling may suppress tumor growth in vivo by modulating immunological characteristics of gallbladder cancer cells. PMID: 25964537
- In the Han Chinese population, genetic variation in PSCA was significantly correlated with susceptibility to colorectal cancer. PMID: 24557062
- rs2294008 polymorphism in the PSCA gene is associated with the risk of bladder cancer. PMID: 25374226
- the results suggest that the PSCA rs2294008 (C>T) polymorphism is a risk factor for bladder cancer development. PMID: 25117309
- PSCA rs2294008 allele A & T was linked with risk of gastric cancer and high-risk gastritis PMID: 25503145
- Accumulating evidence shows an association of PSCA with cancers, such as prostate, gastric, bladder, and pancreatic cancer; however, its expression varies with different cancer types. PMID: 24308679
- PSCA is not a marker for a stem cell population nor is it exclusively expressed in the prostate; the function of PSCA in normal cellular processes or carcinogenesis is currently unknown PMID: 24320701
- expression of PSCA as a cell surface marker increased from benign prostate tissues and High Grade Prostatic Intraepithelial Neoplasias to prostate cancer PMID: 24183365
- PSCA-chimeric antigen receptor T cells may be developed for treatment of prostate cancer. PMID: 24438073
- the T allele of rs2294008, an intronic variant of the PSCA gene at 8q24 that was previously associated with an increased risk of gastric cancer, was inversely associated with a decreased risk of esophageal squamous cell carcinoma. PMID: 24654646
- Our findings demonstrated that rs2294008 and rs2976392 polymorphism of PSCA is a risk-conferring factor associated with increased gastric cancer susceptibility PMID: 24146278
- no clearcut interaction with PSCA SNPs in defining risk of gastric precancerous lesions or cancer PMID: 24023815
- Overexpression of PSCA and Oct-4 might be closely related to the carcinogenesis, progression, metastasis, or invasive potential and prognosis of gallbladder carcinoma. PMID: 23984394
- Data indicate that PSA, PSMA, hK2, PSCA, DD3, and their combinations, combined analysis of PSA and/or hK2 expression in pelvic lymph nodes could predict biochemical recurrence free survival (BRFS) following radical prostatectomy (RP). PMID: 21600799
- A C-allele of rs2294008 at PSCA increased the risk of gastric ulcer. PMID: 23704932
- A significant association has been found between the PSCA Trs2294008-Grs2978974 haplotype and higher risk of gallbladder carcinoma in females, whereas this haplotype conferred significantly lower risk to males. PMID: 23988503
- Of the 10 target genes, PCA3 and PSCA mRNAs were significantly differently expressed in cancerous tissue than in histologically benign tissue of cancerous prostates PMID: 23391636
- Data indicate that RNA silencing of PSCA can inhibit the proliferation and invasiveness properties of prostate cancer PC-3M cells, which may provide a promising therapeutic strategy for prostate cancer. PMID: 21429770
- Results indicate the importance of four gastric cancer susceptibility polymorphisms of IL-10, NOC3L, PSCA and MTRR in the Chinese Han population. PMID: 22796266
- a genotyping study to assess for associations between the PSCA rs2294008 polymorphism and risk of adenomatous polyps and colorectal cancer PMID: 22824379
- study suggested rs2294008 in the PSCA gene to be associated with increased risk of gastric cancer and rs2070803 in MUC1 to play a protective role in a Chinese population PMID: 22938426
- findings suggest that the PSCA rs2294008 C>T polymorphism is a risk factor for gastric cancer, especially in diffuse and noncardia gastric cancer and in Chinese PMID: 22938475
- The two loci of PSCA (rs2294008 and rs2976392) were both significantly associated with gastric cancer susceptibility and in linkage disequilibrium. PMID: 22426141
- intensity of QDs fluorescence remained stable for two weeks (p = 0.083) after conjugation to the PSCA protein, and nearly 93% of positive expression with their fluorescence still could be seen after four weeks PMID: 22778595
- Findings suggest that prostate stem cell antigen (PSCA) rs2294008 C > T and rs2976392 G > A polymorphisms may contribute to the susceptibility to gastric cancer, particular in non-cardia or diffused gastric cancer. PMID: 22481254
- Associations exist between PSCA SNPs and breast cancer susceptibility in Korean women PMID: 22502712
- PSCA is acting as a tumor suppressor in GBC development. PMID: 21936014
- The C allele of rs2294008 at PSCA was associated with increased risk of duodenal ulcer in a recessive model but was associated with decreased risk of gastric cancer. PMID: 22387998
顯示更多
收起更多
-
亞細胞定位:Cell membrane; Lipid-anchor, GPI-anchor.
-
組織特異性:Highly expressed in prostate (basal, secretory and neuroendocrine epithelium cells). Also found in bladder (transitional epithelium), placenta (trophoblasts), stomach (neuroendocrine cells), colon (neuroendocrine cells) and kidney (collecting ducts). Over
-
數(shù)據(jù)庫鏈接:
Most popular with customers
-
-
YWHAB Recombinant Monoclonal Antibody
Applications: ELISA, WB, IHC, IF, FC
Species Reactivity: Human, Mouse, Rat
-
Phospho-YAP1 (S127) Recombinant Monoclonal Antibody
Applications: ELISA, WB, IHC
Species Reactivity: Human
-
-
-
-
-